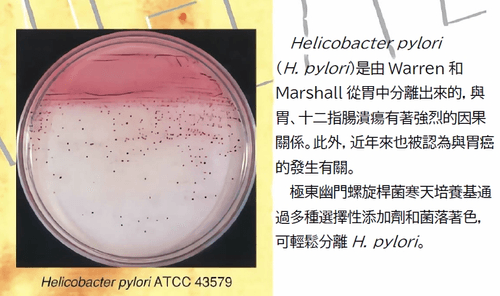
極東公司 H. pylori Agar 幽門螺旋桿菌培養基

返回

極東公司 H. pylori Agar 幽門螺旋桿菌培養基
(H. pylori)是由Warren和Marshall從胃中分離出來的,與胃、十二指腸潰瘍有著強烈的因果關係。
此外,近年來也被認為與胃癌的發生有關。
極東幽門螺旋桿菌寒天培養基通過多種選擇性添加劑和菌落著色,可輕鬆分離H. pylori。
此外,近年來也被認為與胃癌的發生有關。
極東幽門螺旋桿菌寒天培養基通過多種選擇性添加劑和菌落著色,可輕鬆分離H. pylori。



杏友貿易有限公司
LINKSEAS TRADING CO., LTD.


杏友貿易有限公司
LINKSEAS TRADING CO., LTD.

我們專注於國外醫療器材及試劑的代理銷售,並提供臨床實用且具前瞻性的解決方案,協助醫療機構因應多元挑戰
關於杏友貿易有限公司
About Us
Our Mission
We're Hiring!
聯繫我們
我們期待收到您的詢問及關注!
02-27735142
linkseas@gmail.com
lks1976.tw@msa.hinet.net